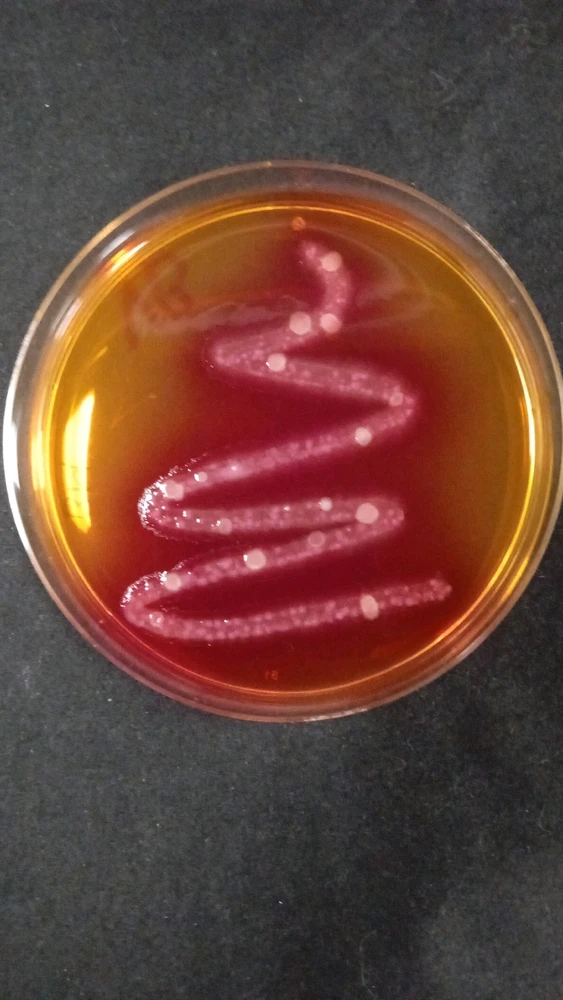
GIF uploaded by Echiniscus

Posted Monday, November 17, 2025
18d
ENTJ
If aliens were found under the ice of Jupiter’s moon Europa, what form of life do you think we’d find?
28 votes
2
1
Science Community
The science community, chat, and discussion.
3.4M SOULS
Meet New People
50,000,000+
DOWNLOADS
Related Posts
23h
ISTP
Virgo
Anyone want to ask questions about Prehistoric animals?
Way too much stuff in my head not to share, can probably answer most things. (edited)
2
8
10d
ESTJ
a experiment
lets see

76
12
1d
INTJ
Libra
High thoughts
So with the advancements in medical research, we can extend human life by 2030 and eventually regenerate cells to keep people at their prime. If we also have the tech to modify our names with gene editing to make ourselves taller, would we just become the elves from lotr?
0
3
13d
ENFP
Scorpio
Graduated teacher in chemistry 🥰❤️

58
17
19d
ISTJ
Virgo
Hibiscus
I'm opening muy inaturalist account

0
0
21d
ESTJ
coding
uh i didnt mean to have that much fun 😳

60
21
10d
INFJ
Taurus
Basalt - 3Ma years old
I'm a sucker for collecting rocks and since I'm studying environmental science this was an EPIC find. A piece of very heavy basalt. From where I found it, the only location it could've come from would've been a 3 million year old magma sill in South Wales. It has tiny pyrite crystals in it if you... read more


21
3
19d
ISFJ
Colorimetricos para entericas
Para la noche de las ciencias hicimos unas placas pa detectar bacterias entericas en lugares comunes
0
5
27d
INTJ
Cancer
Cancer Research.
Is it true that Cancer might be the key to immortality?
3
15
20d
INTJ
Capricorn
If you were allowed to time travel once to change one thing in your life.What would it be?
0
3
10d
INFJ
Cancer
💭🪐Planet Curiosity
🪐What's your topmost favorite planet in our Solar System and Why? ( Yes, that includes Pluto even though it's classification has changed) (edited)

9
24
21d
INFJ
Leo
Some Cool Findings
Without overwhelming you all with the details, basically there is a method to train a transformer model such that it identifies a specific task for a given input. This helps with interpretability and allows for the interesting ability to modify the latent space during inference time or... (edited) read more




5
7
2d
INTP
Sagittarius
Feelings are fast prediction not future memories
Science says It feels like magic. But it’s your brain working overtime behind the scenes. What we call “gut instinct” isn’t supernatural. It’s actually your brain drawing on millions of past experiences to make rapid-fire predictions before your conscious mind even catches up. Neuroscientists... read more

5
2
15d
ENTJ
Aquarius
Tissue Culture
We have cultivated the same species of plants for a while now. However, farming is changing the goal now is to be highly productive with less space. Over a year ago I started reading about different edible plants and how there are plants out there that are edible and more productive than our... read more







10
2
21d
INTP
Taurus
Fox pounce
Foxes tend to pounce in a north easterly direction, supposedly using the earth's magnetic field as a guide via a protein called cryptochrome.

11
3
3d
ENTJ
Aquarius
Mad Science Monday

5
1
29d
INFJ
Pisces
⏱️⏲️⏰🕰️⌛️⏳
November the fifth 1955, a red letter day in science….

10
4
23d
INTJ
Virgo
Do we evolve or adapt?
Dumb question but I've been pondering this (edited)
4
7
15d
INFJ
Leo
Buh
Bug

6
5
29d
INTP
Virgo
Cure for sore feet?
Walking on concrete everyday is doing a serious number to the arches in my feet. I know I need gel insoles but for tonight any suggestions? I've heard epsom salt and warm water helps, so I'm trying that.
2
6
16d
ENTP
Leo
In my lab
3
3
14d
INTP
Scorpio
Life finds a way to be... Interesting

9
1
26d
ISFJ
Gemini
Peak nerd humor.

4
1
26d
ENTP
Libra
What's your conspiracy theory, that u believe in with all of your being
3
2
23d
INTP
Leo
⬇️⬆️ (edited)

3
1
20d
INTJ
Pisces
Okay I had a literal shower thought about the "Last Thrusday" theory
I was thinking about the "Last Thursday" theory (aka the theory where they say that the universe could've been created literally last thursday, we just were created with the memory of there being something before it), and I was thinking -- could there be/have been a species that was created at the... read more
2
13
15d
INFP
Pisces
Three body problems
Today I am in the " three body problems" building in Oxford 🤩

3
2
23d
INTJ
Scorpio
I
3
1
27d
INTP
💡

2
4
7d
INFJ
Sagittarius
Meanwhile, in China...
Also reminds me of what happens when you give a wrong response to a girlfriend/wife 🤔😏
2
2
24d
INTP
Leo
Titration 🩷
One is good, one is meh, and the last is 😣 I hope I did it good tho, and pass the lab act.






3
1
22d
ESTJ
Capricorn
Malam
Time to bed
2
1
13d
INTP
Aquarius
👨🔬
4
1
12d
ENFJ
Leo
AI will revolutionize or will give hike in Unemployment. Add your comments also.
8 votes
2
4
16d
INTJ
Libra
A sensory deprivation chamber is actually a sensory maximization chamber. It's a stimuli deprivation chamber. A real sensory deprivation chamber would be watching Lizzo twerk on a piano. You'd retreat inward from witnessing too much.
Sensory overload. (edited)
3
1
29d
ISTJ
Virgo
Debate
The "miracle healing" of spiritual traditions (think Christianity for example) are nothing more or less than what we now call "the placebo effect". Should we not therefore look into how we can utilise the body's ability to self-heal through consciousness?
2
1
24d
INFJ
Dating AI be like



1
1
1mo
INFJ
Sick and bored
Testing, for science!
17
15